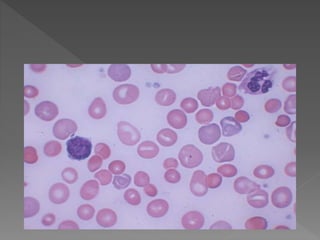

Anaemia is a condition where the number of red blood cells or their oxygen-carrying capacity is insufficient. Globally, anaemia affects 1.62 billion people or 24.8% of the population. In India, around 50% of the population is estimated to have anaemia. The most common cause of anaemia is nutritional deficiency of iron, vitamin B12, or folic acid. Left untreated, anaemia can lead to complications like maternal or infant mortality. Treatment involves oral or injectable iron, vitamin B12, folic acid supplements, or erythropoietin injections depending on the underlying cause.

![ Acidic pH, Ascorbic Acid(Vit-C),
Cysteine
Reduces Ferric[Fe3+] to Ferrous[Fe2+]
Phosphates, Oxalates, Phytates
Milk, Antacid, Tetracyclines (Forms
Insoluble complexes)](https://image.slidesharecdn.com/anaemiaforbscnursing-150806082055-lva1-app6891/85/Anaemia-for-b-sc-nursing-12-320.jpg)







](https://image.slidesharecdn.com/anaemiaforbscnursing-150806082055-lva1-app6891/85/Anaemia-for-b-sc-nursing-20-320.jpg)










